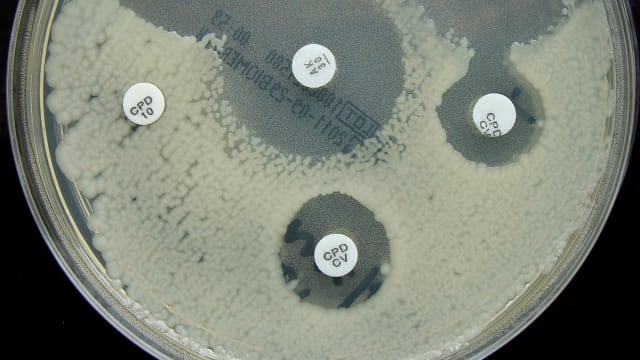
image

Der Bund prüfe die Idee einer Art Gesundheitspolizei, welche in den Spitälern im Bereich der Antibiotika-Resistenzen intervenieren könnte – beispielsweise bei übermässiger Abgabe von Antibiotika durch die Ärzte.
Dies meldet die
«Sonntagszeitung» (Print), wobei sie unter anderem Daniel Koch vom BAG zitiert: «Wir müssen uns grundsätzlich fragen, ob wir in unserem Gesundheitswesen genügend Kontrollen haben», so der Leiter der BAG-Abteilung Übertragbare Krankheiten.
Neue Richtlinien für Spitäler
Ein Vorbild sei dabei Holland, wo der Verbrauch von Antibiotika wie auch die Zahl resistenter Keime innert weniger Jahre deutlich gesenkt wurde, unter anderem mittels staatlichen Kontrollen in den Spitälern.
Parallel dazu beschlossen Infektiologenvereinigung Swissnoso und die Schweizerische Gesellschaft für Infektiologie in der letzten Woche Konzepte für Richtlinien zur Verabreichung von Antibiotika in Spitälern.
Auch Kompetenz zu Sanktionen
«Richtlinien sind ein wichtiges Instrument im Kampf gegen Antibiotikaresistenzen», sagt Swissnoso-Präsident Andreas Widmer in der SoZ. Diese Regeln müssten aber auch überwacht werden. USB-Spitalhygieniker Widmer fordert ein nationales Fachgremium, das die Kompetenz erhalten soll, auch Sanktionen zu ergreifen.
Im Hintergrund steht das bekannte Wachstum von Fällen mit Antibiotika-Resistenzen. Die Lage sei «beunruhigend», so der Leiter des Zentrums für Antibiotikaresistenzen
Anresis, Andreas Kronenburg. Im Jahr 2004 registrierte Anresis hochgerechnet nur 40 Fälle von Blutvergiftungen durch resistente ESBL-Keime – im letzten Jahr waren es bereits rund 300 Fälle.
Der Film: Wie Bakterien Antibiotika besiegen
Ein Experiment der Harvard Medical School zeigt, wie rasch Bakterien resistent werden. Die Forscher nahmen quasi eine «Riesen-Petri-Schale» und zogen dann mehrere Linien mit immer stärkeren Dosen eines Antibiotikums (Trimethoprim).
Die E.Coli-Kultur konnte an einer Stelle beginnen, die für sie «sauber» war. Nach gewissen Verzögerungen gelang es den Bakterien, die jeweils stärkere Dosis zu überwinden.
Nach nur elf Tagen hatten sie es geschafft, eine Trimethoprim-Ladung zu überleben, die 1'000mal stärker war als die Anfangsdosis.